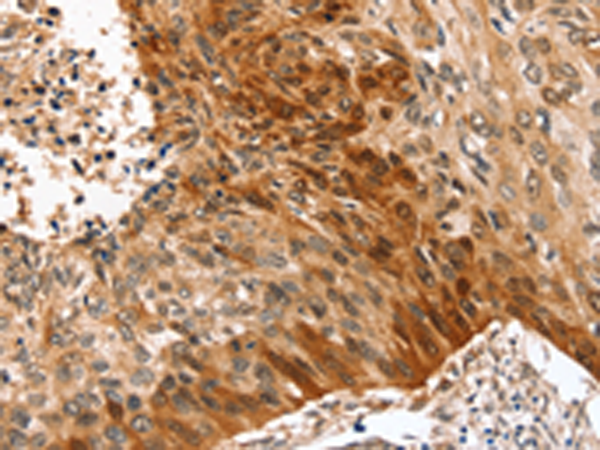

-
分类: 科研抗体货号: P12246别名: FEX1; FEEL-1; FELE-1; STAB-1; CLEVER-1应用: IHC反应种属: Human, Mouse
-
分类: 科研抗体货号: P12245别名:应用: WB反应种属: Human
-
分类: 科研抗体货号: P12262别名: SNT1; LQT12; TACIP1; dJ1187J4.5应用: WB,IHC反应种属: Human, Mouse
-
分类: 科研抗体货号: P12244别名: ES; ASC; XLI; ARSC; SSDD; ARSC1应用: WB,IHC反应种属: Human
-
分类: 科研抗体货号: P12261别名: EPM; EPIM; STX2A; STX2B; STX2C应用: WB,IHC反应种属: Human, Mouse, Rat
-
分类: 科研抗体货号: P12243别名: La; LARP3; La/SSB应用: WB,IHC反应种属: Human
-
分类: 科研抗体货号: P12259别名: ENV; ENVW; HERVW; ERVWE1; HERV7Q; HERV-7q; HERVWENV; HERV-W-ENV应用: IHC反应种属: Human
-
分类: 科研抗体货号: P12242别名: FNBP2; SRGAP3; SRGAP2A; ARHGAP34应用: IHC反应种属: Human, Mouse, Rat
-
分类: 科研抗体货号: P12258别名:应用: IHC反应种属: Human
-
分类: 科研抗体货号: P12240别名: CCDC99应用: IHC反应种属: Human

鄂公网安备42018502007531号
鄂公网安备42018502007531号

